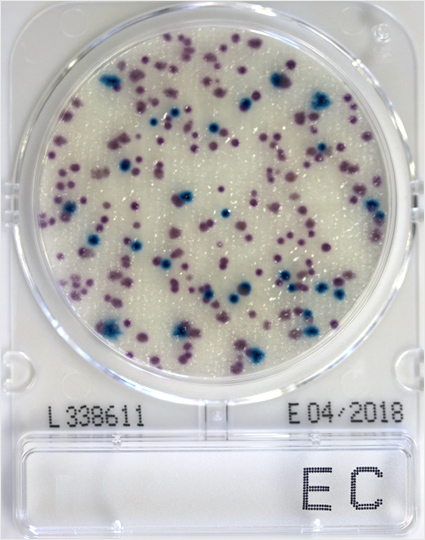
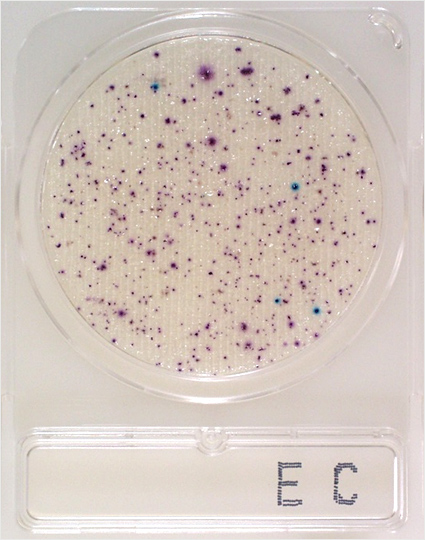
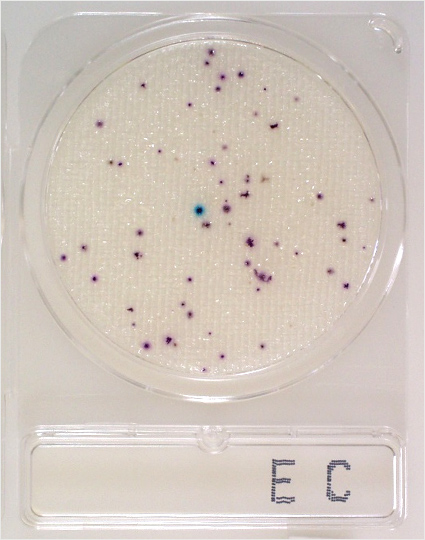
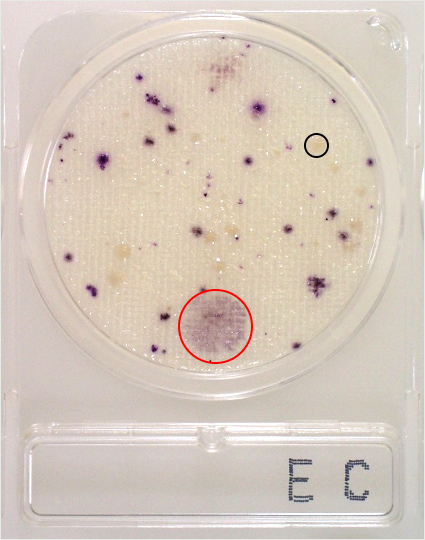

コンパクトドライ™ 判定ガイドコンパクトドライ™ EC
本ガイドは、コンパクトドライ™ ECの培養結果について適切に理解していただくためのものです。その他の製品については以下をご参照ください。
コンパクトドライ™ EC
| 用途 | 大腸菌・大腸菌群数測定用 |
|---|---|
| EC | Escherichia coli & Coliform Count |
| 認証 | 食品衛生検査指針2018収載/AOAC-PTM認証/MicroVal認証/NordVal認証 |
| 特長 | ・2種類の発色酵素基質(X-GLUC、MAGENTA-GAL)により、大腸菌と大腸菌群を区別して計測 |
| 判定方法 | 培養温度 35±1℃ 培養時間 24±2時間 大腸菌 :青~青紫色コロニー 大腸菌群:ピンク~赤紫色コロニー 大腸菌群数は青色と赤色の合計コロニー数をカウントします。 |
※大腸菌は特異的に産生するβ-グルクロニダーゼにより、酵素基質X-GLUC(5-ブロモ-4-クロロ-3-インドリル-β-D-グルクロニド)を分解して青色色素を生成して青~青紫色コロニーを形成します。
※大腸菌群はβ-ガラクトシダーゼにより、酵素基質MAGENTA-GAL (5-ブロモ-6-クロロ-3-インドリル-β-D-ガラクトピラノシド)を分解して赤色色素を生成し、大腸菌以外の大腸菌群はピンク~赤紫色コロニーを形成します。
発色酵素基質によるコロニーの発色
鶏むねひき肉103倍希釈では多くの大腸菌群の中に青く発色した大腸菌が認められます。
大腸菌を計測する場合は103倍希釈を、大腸菌群を計測する場合は、もう一段階希釈倍率の高い104倍希釈を用いて数える必要があります。

Q 黒丸で示したような黄色(茶色)のコロニーはカウントすべきコロニーですか?
A 酵素基質による発色がないコロニーはカウント対象外です。大腸菌・大腸菌群以外のグラム陰性桿菌と思われます。
Q 赤丸で示したようなうすい広がったコロニーはどうですか?
A 赤い発色が薄いコロニーもカウントしてください。

ヨーグルト中の多くの乳酸菌(β-ガラクトシダーゼ産生)により、菌の発育を待たず検体接種後数十分でシート全体が赤紫色に着色します。このような特定酵素を多量に含む食品の検査には不向きです。
ポイント
青と赤が混ざった中間色コロニーが現れる場合がありますが、同一シート内の他の赤色コロニーと比べて青色が混ざっていればβ-グルクロニダーゼを産生しているとし、大腸菌と判定してください。